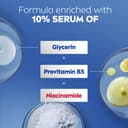
Thumbnail 6

💧 Unlock 48 hours of unstoppable hydration and skin revival!
NIVEA Intense Healing Body Lotion delivers dermatologist-approved, ultra-long lasting moisture for up to 48 hours. Powered by Provitamin B5 and HYDRA IQ Technology, it repairs and nourishes dry, tight skin with a non-greasy, fast-absorbing formula free from artificial colors and animal ingredients—perfect for the conscious, modern professional.





| ASIN | B00DG8EZKO |
| Active Ingredients | carbomer,cetearyl alcohol,glycerin,glyceryl stearate,isopropyl,panthenol,phenoxyethanol,provitamin b5,sodium hydroxide |
| Age Range Description | Adult |
| Benefits | Moisturizing |
| Best Sellers Rank | 168,086 in Beauty ( See Top 100 in Beauty ) 2,208 in Body Lotions |
| Brand Name | NIVEA |
| Container Type | Bottle |
| Country as Labeled | United States |
| Customer Reviews | 4.7 4.7 out of 5 stars (27,753) |
| Is Tinted | No |
| Item Dimensions | 8.3 x 5 x 24 centimetres |
| Item Form | Lotion |
| Item Volume | 500 Millilitres |
| Item Weight | 16.9 Ounces |
| Manufacturer | Nivea |
| Manufacturer Part Number | U-BB-2351 |
| Material Features | Fragrance Free |
| Material Type Free | Artificial Colour Free |
| Model Name | U-BB-2351 |
| Model Number | U-BB-2351 |
| Number of Items | 1 |
| Other Special Features of the Product | Homeopathic |
| Recommended Uses For Product | Dryness |
| Scent Name | Unscented |
| Skin Type | Dry |
| Special Ingredients | Glycerin, Water, c15-19, cetearyl alcohol |
| Specific Uses For Product | Dryness |
| Target Use Body Part | Body |
| UPC | 072140011529 |
| Unit Count | 499.79 millilitre |
B**5
Very moisturising
Lovely, really moisturising.
P**L
Good value
Good value
A**R
Love this product
First of all the item was delivered on the day... so no delays courier was polite and helpful, as I have a fractured Femur I cannot lift or carry ... loving the product it is amazing as I cannot bath fully the moisturiser is helping to keep my skin from drying out but it is not creasy and easily absorbs into the skin.. definitely a no1 in my bathroom......
F**A
Excellent hydration. I have rough/dry skin and this is the only lotion that fixed my skin issues.
J**.
I have a very dry skin. Other lotions wont last a day. But when I started using this product daily, I don’t have dry skin anymore. Haven’t tried it for every 72hrs (it mentioned it last for 72hrs) but im good using it daily. 👍
M**T
Excellent
B**S
Actually I bought it for my mother who is 85 years old.She had very dry skin.This body lotion was very helpful.
A**R
Why has the price been increased so much....from 1800 to 2400+?
ترست بايلوت
منذ شهر
منذ 3 أيام